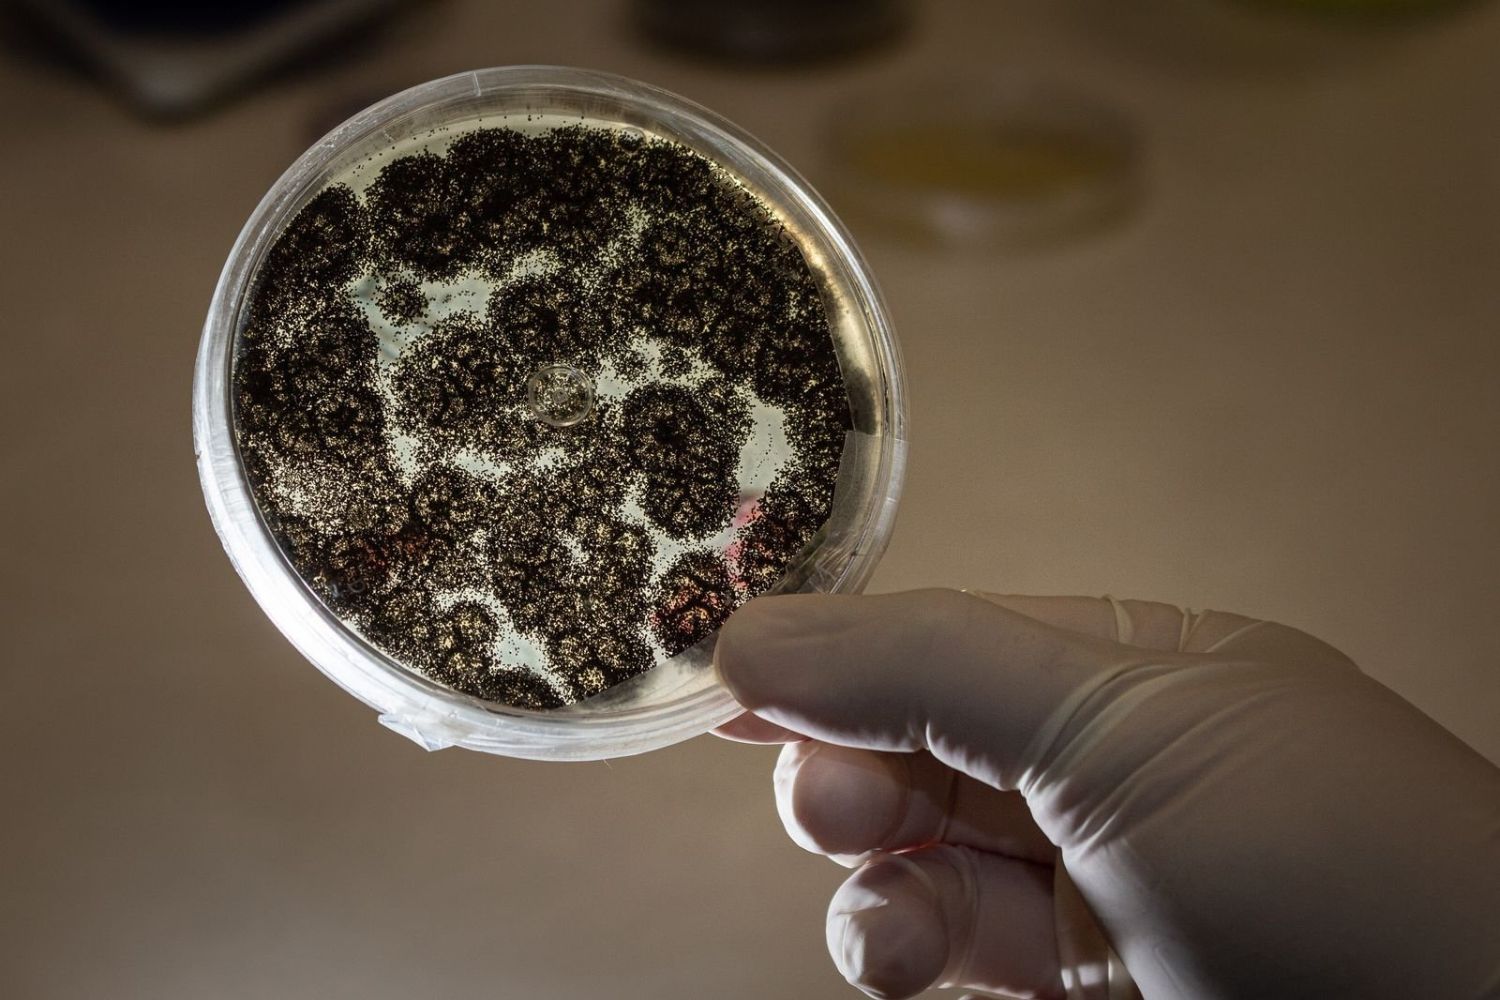
O que existe na névoa da Amazônia pode mudar o que sabemos sobre a floresta

A Amazônia sempre foi vista como um sistema complexo, onde cada elemento desempenha um papel essencial. Mas há processos invisíveis acontecendo acima das copas das árvores que só agora começam a ser compreendidos. Entre partículas suspensas e fenômenos atmosféricos discretos, pesquisadores identificaram algo inesperado — e que pode ajudar a explicar como a floresta se mantém viva e em constante regeneração.
Um fenômeno invisível que ganhou nova importância
Um estudo internacional trouxe à tona um mecanismo pouco explorado: a capacidade da névoa amazônica de transportar microrganismos vivos. Mais do que simples partículas suspensas no ar, essas gotículas funcionam como veículos naturais que carregam vida por longas distâncias.
A pesquisa reuniu dezenas de cientistas de diferentes áreas, incluindo biologia, química e meteorologia. Juntos, eles analisaram amostras coletadas em uma região preservada da Amazônia e encontraram evidências claras de que bactérias e fungos conseguem sobreviver nesse ambiente.
Entre os organismos identificados estão espécies conhecidas por atuar na decomposição da matéria orgânica — um processo fundamental para o ciclo de nutrientes da floresta.
A névoa como um “transporte biológico”
O que torna esse fenômeno ainda mais interessante é a forma como ele acontece. As gotículas de névoa não apenas carregam esses microrganismos, mas também oferecem proteção contra condições adversas, como radiação ultravioleta e desidratação.
Isso cria um ambiente favorável para que esses seres sobrevivam durante o transporte. Quando a névoa se desloca e eventualmente se dissipa, esses microrganismos podem se depositar em novas áreas e colonizar diferentes partes da floresta.
Os pesquisadores chegaram a descrever esse processo como uma espécie de “elevador biológico”, capaz de levar partículas e organismos das camadas mais baixas até regiões acima das copas das árvores — e além.
Descobertas feitas acima das copas das árvores
A coleta das amostras aconteceu em um ponto estratégico: uma torre de observação com mais de 300 metros de altura, localizada em uma área protegida da Amazônia. Foi ali que os cientistas conseguiram capturar gotas de névoa nas primeiras horas da manhã.
Esse período é crucial, já que a formação da névoa ocorre quando o ar úmido se resfria. Com o nascer do sol, correntes de ar elevam essas partículas, permitindo que elas se espalhem pelo ambiente.
Ao analisar as amostras, os pesquisadores identificaram milhares de células por mililitro de água. Muitas delas estavam metabolicamente ativas, com DNA preservado — o que indica que não eram apenas vestígios, mas organismos vivos.
Uma diversidade maior do que se imaginava

Os estudos laboratoriais revelaram uma variedade significativa de microrganismos, incluindo diferentes espécies de bactérias e fungos. Essa diversidade não apresentou uma relação direta com as estações do ano, o que sugere que o fenômeno pode ocorrer de forma contínua.
Isso levanta uma hipótese importante: a névoa pode ser um dos mecanismos responsáveis pela distribuição desses organismos em toda a floresta, contribuindo para manter o equilíbrio ecológico.
Como muitos desses microrganismos participam da decomposição de matéria orgânica, eles desempenham um papel essencial na reciclagem de nutrientes — um processo vital para o crescimento das plantas.
Impactos ainda em estudo
Apesar do entusiasmo com a descoberta, os cientistas destacam que ainda há muitas perguntas em aberto. Não está totalmente claro até que ponto esses microrganismos influenciam diretamente processos como a decomposição no solo.
Alguns especialistas sugerem que o principal efeito da névoa pode estar relacionado ao aumento da umidade, criando condições favoráveis para a atividade biológica. Outros acreditam que o transporte de organismos pode ter um impacto mais direto do que se imagina.
Para esclarecer essas questões, novas pesquisas estão sendo planejadas, incluindo experimentos que comparam ambientes com e sem a presença desses microrganismos.
O que vem a seguir
Os próximos passos envolvem análises mais detalhadas das amostras coletadas. Os pesquisadores pretendem sequenciar o DNA presente na névoa e investigar a composição química das partículas associadas.
A expectativa é revelar uma diversidade ainda maior de microrganismos e compreender com mais precisão como eles interagem com o ecossistema amazônico.
Estudos anteriores já indicavam que partículas atmosféricas podem transportar nutrientes essenciais, como nitrogênio, ferro e fósforo, ao longo de grandes distâncias. Agora, essa nova descoberta amplia ainda mais a compreensão sobre os processos invisíveis que sustentam a floresta.
Um novo olhar sobre a Amazônia
O que antes parecia apenas um fenômeno climático comum pode, na verdade, ser parte de um sistema sofisticado de manutenção da vida. A névoa amazônica, discreta e muitas vezes ignorada, pode desempenhar um papel fundamental na regeneração do ecossistema.
Essa descoberta reforça uma ideia que vem ganhando força na ciência: a de que a Amazônia funciona como um organismo integrado, onde até os elementos mais sutis têm impacto significativo.
E, à medida que novos estudos avançam, fica cada vez mais claro que entender esses processos invisíveis pode ser essencial para proteger um dos biomas mais importantes do planeta.
[Fonte: Meteored]






